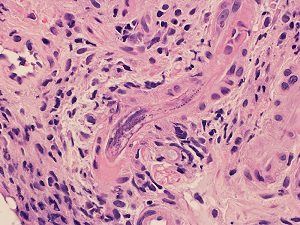
Case470_E parasitic image

Case #470 – June, 2018
A 51 year-old immigrant man from Honduras was prescribed steroids at a health care facility for asthma exacerbation. After feeling better, he continued to self-medicate with injectable steroids every three months obtained via mail order from Honduras for approximately one year. He returned to the health care facility with symptoms including abdominal pain, worsening fatigue, shortening of breath and bright red rectal bleeding. Figures A–E are from hematoxylin-and-eosin stained sections of biopsies taken from the terminal ileum to the rectum (do not let the “sugar skull” in Fig A distract you!). Figures F–H are from a stained (presumably Papanicolaou) cytospin smear of a sputum specimen. What is your diagnosis? Based on what criteria?
This case and images were kindly provided by the Department of Pathology and Laboratory Medicine at the University of Texas/McGovern Medical School, Houston, Texas

Figure A

Figure B

Figure C

Figure D
Figure E

Figure F

Figure G

Figure H
Images presented in the dpdx case studies are from specimens submitted for diagnosis or archiving. On rare occasions, clinical histories given may be partly fictitious.
DPDx is an educational resource designed for health professionals and laboratory scientists. For an overview including prevention, control, and treatment visit www.cdc.gov/parasites/.